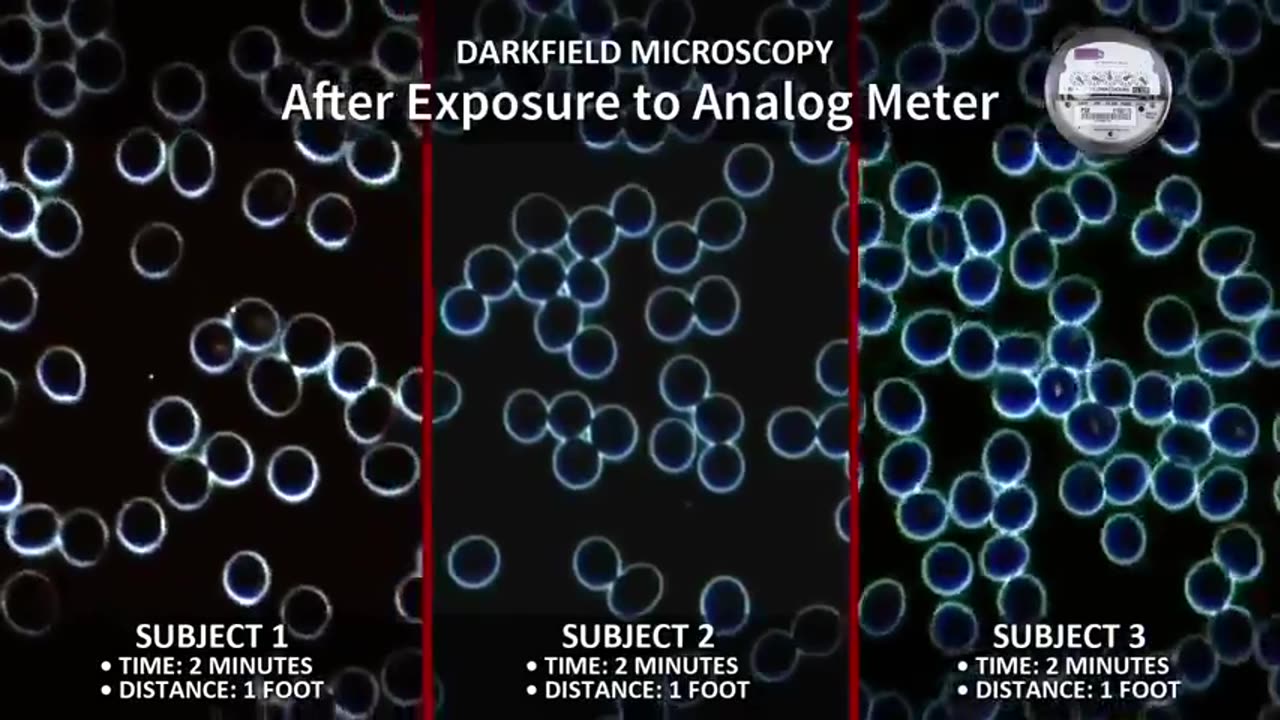

Premium Only Content
This video is only available to Rumble Premium subscribers. Subscribe to
enjoy exclusive content and ad-free viewing.
Take Back Your Power - Smart Meter Documentary
Loading comments...
-
 LIVE
LIVE
Spartan
2 hours agoBack from worlds. Need a short break from Halo, so single player games for now
28 watching -
 LIVE
LIVE
Eternal_Spartan
9 hours ago🟢 Eternal Spartan Plays FF7 Rebirth Episode 15 | USMC Veteran
36 watching -
 LIVE
LIVE
Tundra Tactical
1 hour agoProfessional Gun Nerd Plays Battlefield 6
40 watching -
 1:00:08
1:00:08
BonginoReport
4 hours agoDark Brandon Returns - Nightly Scroll w/ Hayley Caronia (Ep.164)
95.3K42 -
 49:24
49:24
Donald Trump Jr.
5 hours agoPeter Navarro Went to Prison So You Won't Have to | TRIGGERED Ep,286
30.8K37 -
 LIVE
LIVE
Nerdrotic
13 hours ago $1.00 earnedNerdrotic at Night 528
328 watching -
 LIVE
LIVE
xxTOWERDOGxx
1 hour ago👻🔪What's Your Favorite Scary Movie?👻🔪🟢Alienware Area 51🟢!discord🟢
28 watching -
 LIVE
LIVE
LFA TV
1 day agoLIVE & BREAKING NEWS! | MONDAY 10/27/25
576 watching -
 LIVE
LIVE
Kst0ne13
1 hour ago🔥1 day before the BF6 BR! Time to get ready!!
20 watching -
 LIVE
LIVE
ZWOGs
34 minutes ago🔴LIVE IN 1440p! - Horror Games w/ The Brrrap Pack! - Come Hang Out!
29 watching